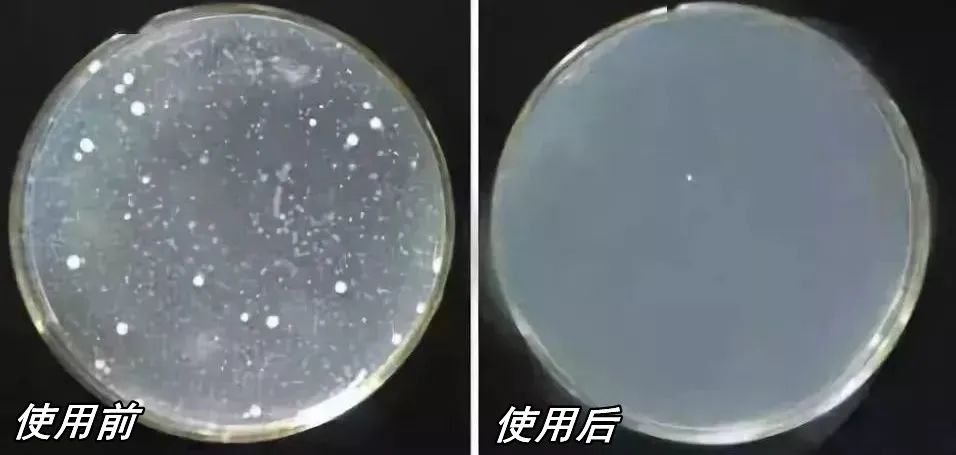
内衣去尿渍洗涤液是骗人的吗,内衣杀菌洗涤剂

相信不少女生都曾受过妇科病的困扰,但是 你们知道吗? 引起妇科病的元凶就在你每天都接触的物品里。它就是:
*裤内**!
世界卫生组织曾发出警告: 女性百分之80的妇科疾病反复发作,与*裤内**有关!
据一组研究数据表示,每条*裤内**平均就留有0.1g的粪便(最多10g),而1克粪便中含有1000万个病毒,100万个细菌、1000个寄生虫包囊……
而这些,就是女性*处私**瘙痒、红肿和异味的罪魁祸首。
如果想预防,还做不到穿一条扔一条的暴富行为,唯一能做的就是:洗干净它!但不是用热水+内衣专用皂+暴晒,这种方法根本无法扼杀细菌。
那要怎么清洗才干净呢?别着急!给你们介绍一款LA SOW最新推出的宝藏好物。
泡一泡就能消灭病菌的内衣清洗液——LA SOW贴身衣物洗涤慕斯
高颜值,轻奢香型
用一次都爱上洗内内了~

它的成分很不一般
针对最常见引起妇科病的三大“*处私**嗜肉菌”:
(金黄色葡萄球菌、白色念珠菌、大肠杆菌),
轻松杀死有害病菌,达到长效抑菌!

PH值检测也完全符合
*处私**的 弱酸性环境
用起来放心很多
低泡配方+慕斯泡沫
更容易清洗,洗后无残留

去污能力更是没话说
血渍、尿渍、分泌物泡一泡
轻搓2下全部消失了

它的味道超好闻
特调的高级香氛
不仅除异味
洗过后内衣裤还散发着清香

LA SO贴身衣物洗涤慕斯
1瓶=洗衣液+抑菌液+香水
这性价比真的高到没话说

3倍去污渍
血渍、分泌物全拜拜
有多少女生因为经期*裤内**染血
洗不掉而不得不丢掉?
血渍实在很令人头疼!

普通洗液浸泡一天血渍都无法洗掉
而LA SOW这款专业洗涤慕斯
添加靶向性蛋白酶
和阴离子表面活性剂
深入*裤内**纤维
准确锁定并分解污渍

沾到血渍的*裤内**
浸泡2-3分钟后
轻轻一搓立马干净
要是不小心染到床单
也可以挤一点点上去搓一搓
用湿巾擦一下就干净了

由于成分是自然椰油精华
温和无刺激,孕婴可用
所以宝宝沾到奶渍、便便等的衣服
都可以放心地清洗

只需轻轻一泵
*裤内**、床单、内衣、宝宝衣服上的污渍
全部缴械投降

长效抑菌,不给菌群留活口
除了要清除掉内衣上看得见的污渍
还要击杀看不见的病毒细菌
从根本上预防妇科疾病的发生
LA SOW贴身衣服洗涤慕斯
添加了 专业抗菌成分
能有效去除大肠杆菌、白色念珠菌
金黄色葡萄球菌、螨虫等
很多外表看似干净的内衣
实际剪开会发现都发霉了
里面爬的全是虫子

这时候派LA SOW洗涤慕斯上场
瞬间消灭污点和霉菌
穿起来更放心

洗*裤内**更不用说了
不再有螨虫病菌残留
还能长效持久抑菌
防止细菌二次滋生
抵抗霉菌高发
如果有瘙痒情况的
你会发现用它 洗上2次*裤内**
*处私**瘙痒、异味都能慢慢得到改善


健康配方,轻柔呵护
大多数人都还在用 皂类洗*裤内**
不仅裆部会越洗越硬
还破坏*处私**酸碱平衡
碱基皂基残留对*处私**危害大
LA SOW为了达到良好去污效果
同时不伤害*处私**情况下
采用了自然椰油精华和橄榄油提取物
衣物洗后柔软有弹性

不仅可以洗内衣
各种 棉麻,纤维,混纺,高级羊毛衫 都可以洗

采用科学调配,弱酸性配方
贴合肌肤PH值,温和不伤手
还能够更好的守护*处私**

不伤手的同时
植物低泡更易清洗
过水即清,省水又省力

用在*处私**的地方,配方都会更加严谨
这款洗涤慕斯 完全没有添加荧光剂
也没有 任何香精、色素、皂基、增稠剂
孕妇、宝宝皆可放心使用~


两种香型 邂逅芬芳
在香气的造诣上
它也做到了十足撩人
清新的花香在阳光的催发下氤氲
柔软细腻的衣物香气迷人
令人倍感安心
心情也跟着香气愉悦了不少

光影缪斯
前调:黑加仑、红醋栗、香柠檬
中调:茉莉、小苍兰、鸢尾花、玫瑰
后调:麝香、广藿香

这个香型是 甜美花果香调
与蒂芙尼钻石同款香味
初闻是俏皮可爱的黑加仑味
轻盈的果香裹着一层茉莉花香
玫瑰迎着一同出场
广藿香打底干净而通透
散发着新鲜又蓬勃的香气
味道甜美又活泼
是积极阳光的女孩
如果你喜欢偏果香味
可以选择这个味道
会带给你青春的力量

苏醒之旅
前调:粉红胡椒、橙花、梨
中调:咖啡、茉莉、杏仁、甘草
后调:香草、广藿香、雪松、开司米木

这个香型是 辛辣东方香调
与YSL黑*片鸦**同款香味
初闻一股甜甜的橙花香
微微有点辛辣
一种放荡不羁的感觉
随着时间推移转化为花香味
后调中加入了沉稳的木质香
味道香甜又性感
可酷可甜,少女与成熟兼具
如果你喜欢偏花香味
可以选这个味道
会带给你自信的力量